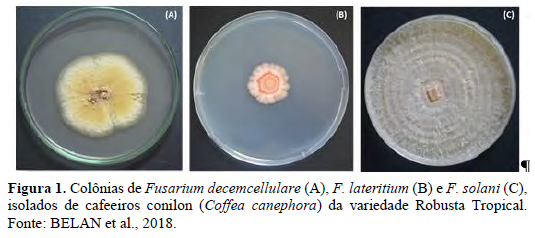

Murcha de Fusarium em Cafeeiro Conilon: Entender Para Manejar
Introdução
O Brasil é o maior produtor e exportador de café (Coffea spp.), contribuindo com 33% da produção mundial, e o segundo maior produtor da espécie Coffea canephora Pierre ex. Froehn, sendo o maior produtor o Vietnã e em terceiro a Indonésia (USDA, 2019, CONAB, 2019).
O consumo mundial de café solúvel aumenta a cada ano, sendo o uso do café conilon (C. canephora), essencial para o seu preparo, geralmente na proporção de 40%, mas esta proporção pode variar em função da produção anual (ABICS, 2019, ABIC, 2019).
O Brasil é o principal exportador de café solúvel. Os principais consumidores desses cafés são Filipinas, China e Russia. (USDA, 2019). Logo, a produção de café conilon pode influenciar desde a composição dos produtos finais, até no preço dessa commodity no mercado e consequentemente na economia mundial.
A produção de café conilon pode ser afetada por diversos fatores, sendo as doenças de plantas um dos mais importantes.
A ocorrência de doenças é um desafio aos produtores, técnicos e governo, pois as doenças causam danos nas lavouras e consequentemente perdas aos produtores rurais e ao estado, além da necessidade precoce da substituição da lavoura por um novo plantio.
Entre as doenças fúngicas, a Murcha de Fusarium em Cafeeiro Conilon (MFCC), cujo agente etiológico foi relatado recentemente por Belan et al. (2018), está preocupando os produtores por causar a morte das plantas e consequentemente ocasionar prejuízos aos produtores.
Até o momento foram relatadas três espécies de Fusarium (F. decemcellulare; F. lateritium e F. solani) patogênicas ao cafeeiro conilon no Brasil (Belan et al., 2018).
Outras espécies de Fusarium foram relatadas em Coffea spp. em países do continente africano, bem como em Porto Rico, Ilhas Virgens e Costa do Marfim; mas o relato de Belan et al. (2018) foi o primeiro no Brasil dessas três espécies como agentes etiológicos da doença em C. canephora.
Os sintomas desta doença nas plantas observados em campo são: redução do vigor, murcha e amarelecimento das folhas, desfolha, escurecimento dos tecidos vasculares, seca e morte de ramos plagiotrópicos e ortotrópicos, culminando na morte das plantas.
Em variedades suscetíveis essa doença pode causar danos de até 100%, além de inviabilizar a área para plantios futuros.
Para o manejo correto desta doença é necessário desenvolver estudos epidemiológicos do patossistema em questão, uma vez que, pouco se conhece do mesmo até o momento.
Assim, conhecer a distribuição espaço-temporal da MFCC nas lavouras e determinar seus parâmetros epidemiológicos (taxa de progresso, padrão de distribuição espacial, etc.), são essenciais para propor estratégias de manejo eficientes, a fim de evitar danos e perdas, visto que este patossistema é de difícil manejo.
Devido ao atual relato desta doença no Brasil e sua importância para cafeicultura, neste capítulo buscamos reunir as informações existentes até o momento para auxiliar aos produtores, técnicos e governo a entender esse patossistema para que possamos propor técnicas eficientes para o manejo.

Etiologia
Para que medidas adequadas e viáveis sejam tomadas em planos de manejo fitossanitário, a correta identificação e detecção dos agentes etiológicos constituem-se em etapas críticas.
O conhecimento aprofundado acerca das características morfológicas, fisiológicas e genotípicas dos fitopatógenos pode ser muito útil a depender do potencial discriminatório dos caracteres investigados.
Essa última observação é determinante, sobretudo para os casos de doenças associadas a múltiplos agentes etiológicos o que configura os patossistemas de alta complexidade.
Nos últimos anos, a doença aqui referida como Murcha de Fusarium do Cafeeiro Conilon (MFCC) que acomete o sistema vascular do cafeeiro ocasionando à murcha e morte das plantas, têm preocupado cafeicultores das regiões consideradas os celeiros da cultura, como Espírito Santo, Minas Gerais, Bahia e demais estados produtores de Café conilon.
Em investigações recentes, a MFCC foi atribuída a três espécies do gênero Fusarium (F. solani, F. lateritium e F. decemcellulare), capazes de induzir sintomas similares àqueles visualizados em campo quando inoculadas em mudas de café conilon sadias (Belan et al., 2018).
As culturas de Fusarium spp. associadas a MFCC em cafeeiros conilon do Estado do Espírito Santo possuem tipos morfológicos contrastantes, por exemplo, colônias de F. decemcellulare apresentam aspecto cotonoso, coloração que varia de amarelo a creme (Figura 1A), macroconídios fusiformes com quantidade de septos que varia de 6 a 9 e microconídios hialinos, ovais, com uma papila basal achatada e de 0 a 1 septo.
As colônias de F. lateritium apresentam micélio de coloração branca à cor de pêssego (Figura 1B), macroconídios septados, com número de septos que variam de 3 a 5 e microconídios fusiformes com 0 a 1 septo.
Colônias de F. solani apresentam micélio de coloração que varia de branco ao creme (Figura 1C), macroconídios hialinos com 3 septos e microconídios hialinos, unicelulares e oblongos, com número de septos que varia de 0 a 2 (Belan et al., 2018).
Um ampla diversidade de espécies de Fusarium, incluindo F. oxysporum, F. solani, F. verticillioides, F. equiseti e F. stilboides, F. dimerium já foi amostrada a partir de raízes, folhas, galhos, troncos, frutos e sementes de plantas de cafeeiro com sintomas de murcha no Brasil (Minas Gerais) (Pfenning, Silva, 1999; Pfenning, Martins, 2000; Almeida et al., 2003) e em Uganda, as espécies F. xylarioides, F. stilboides, F. solani, F. lateritium, F. oxysporum, F. moniliforme, F. semitectum e F. acuminatum tem sido recuperadas de frutos, raízes e ramos de plantas de cafeeiro conilon que apresentam murcha que culmina com o declínio dessas plantas (Serani et al., 2007).
Dessas oito espécies relatadas para o continente africano, cinco tiveram a patogenicidade confirmada em cafeeiro, sendo F. xylarioides a mais agressiva das espécies quando inoculada em plantas de cafeeiro conilon, além de F. lateritium, F. solani, F. oxysporum e F. stilboides (Waller, Holdeness, 1997; Serani et al., 2007; Baker, 1972; Gordon, 1956; Wrigley, 1988; Wellman, 1954).
No Brasil, a patogenicidade de Fusarium spp. foi comprovada apenas para as espécies F. solani, F. lateritium e F. decemcellulare, o que não exclui a amplitude da gama de fitopatógenos associados a MFCC no país, à medida que novas coletas sejam realizadas no futuro.
Como já mencionado, espécies de Fusarium associadas a plantas acometidas pela MFCC possuem ampla distribuição em relação aos tecidos do hospedeiro, podendo colonizar ramos, folhas, raízes, frutos e sementes, sendo essa última habilidade, uma das mais alarmantes por se tratar de um modo eficiente para disseminação de fitopatógenos a longa distância.
Tanto F. solani quanto F. oxysporum puderam ser recuperadas a partir de sementes de C. arábica provenientes de plantas com murcha e de um lote de sementes comerciais (Almeida et al., 2003).
Pouco sabemos se no campo ocorre algum tipo de sucessão de espécies de Fusarium fitopatogênicas, ou mesmo se outros patógenos primários ou a própria ação antrópica seriam críticos para a patogênese das três espécies até então comprovadamente responsáveis pela MFCC.
Aparentemente, a segunda hipótese que sugere a participação de um agente de disseminação, que facilita a entrada dos fitopatógenos, incluindo o homem, parece ganhar força, já que segundo Belan et al. (2018), espécies distintas, isoladamente, são capazes de promover a morte das plantas após a inoculação de tecidos com ferimentos.
Um dos principais entraves atrelados a etiologia e diagnose da MFCC, reside na necessidade da inclusão dos postulados de Koch em futuros testes diagnósticos em Clínicas Fitopatológicas e Laboratórios credenciados, considerando que o teste de patogenicidade, nesse caso, não fornece resultados em tempo hábil para tomadas de decisão.
Esse procedimento é indispensável, pois a microflora de cafeeiros, é enriquecida com os cosmopolitas do grupo Fusarium spp., incluindo os não fitopatogênicos (estritamente endofíticos e/ou epifíticos) (Venkatasubbaiah, Safeeulla, 1986).

Há relatos da presença de F. oxysporum como endofítico em ramos de cafeeiro (C. arábica) sem sintomas de murcha (Almeida et al., 2003).
A diagnose rápida, sensível e específica desses patógenos, através de métodos de detecção de ácidos de nucléicos quantitativos como a qPCR (quantitative Polymerase Chain Reaction) ainda não tem sido possível, pois esse patossistema de extrema complexidade, carece de informações detalhadas sobre a genômica dos fitopatógenos associados a MFCC no Brasil.
Como atualmente não dispomos de marcadores e/ou sondas específicas, a atribuição dos sintomas da MFCC a isolados de Fusarium spp. obtidos em cafeeiro com sintomas deve ser criteriosa e cautelosa.
Há uma necessidade urgente de caracterização molecular robusta desses agentes etiológicos para assistir a busca por assinaturas/marcadores moleculares que possibilitem contrastar o fingerprint de isolados/espécies patogênicas ou não ao cafeeiro conilon.
Análises mais detalhadas sobre as espécies de Fusarium associadas à MFCC estão sendo conduzidos para atender os critérios contemporâneos da taxonomia e nomenclatura dos espécimes baseados em filogenia.
Todos esses esforços irão facilitar o desenvolvimento de um procedimento operacional padrão (POP) para correta identificação desses fitopatógenos.
Sintomatologia
O conhecimento da sintomatologia (sintomas e sinais) da MFCC é primordial para a correta diagnose. A sintomatologia da MFCC assemelha-se as a descrita por Steyaert (1948) em lavouras de C. arábica, diagnosticadas com murcha tendo como agente etiológico o fungo F. xylarioides.
As plantas com MFCC infectadas por Fusarium spp. (F. solani, F. decemcellulare e F. lateritium) (Belan et al, 2018) apresentam sintomas que se estendem desde o sistema radicular até o ápice das plantas.
Os sintomas se iniciam com clorose generalizada das folhas, coloração que varia de verde clara a amarela do limbo foliar, assim como nos pecíolos e ramos mais jovens.
Simultaneamente, ocorre a perda da turgescência/murcha (Figura 1A), sintoma este visível principalmente nos tecidos foliares, devido à redução do translocamento de água e nutrientes ocasionada pela colonização pelo patógeno dos vasos condutores de seiva do cafeeiro (Figura 1C).

Cancros ou fendilhamentos também ocorrem nos ramos ortotrópicos de alguns clones de cafeeiros conilon.
Com o progresso da doença, ramos ortotrópicos e plagiotrópicos, folhas e frutos secam completamente e morrem (Figura 1B). Geralmente brotações novas que surgem da base de plantas doentes, murcham, secam e morrem precocemente.
Todos esses sintomas podem ocorrer em um ou poucos ramos ortotrópicos, ou pode ocorrer de forma generalizada na planta. Com a seca total dos ramos ortotrópicos, o sistema radicular começa a apodrecer, culminando em morte da planta.
O escurecimento do sistema vascular é também um sintoma característico em plantas infectadas por Fusarium spp. (Figura 1C).
Em plantas de cafeeiros conilon o escurecimento do xilema pode ser observado iniciando-se em raízes de maior calibre, região do colo da planta (± 50 cm acima do nível do solo), e de forma ascendente se estendendo em direção ao ápice da planta.
Diagnose
A MFCC pode ser confundida com outras doenças cujos agentes causais podem ser abióticos (déficit hídrico, deficiência nutricional) ou bióticos o que dificulta a diagnose.
Os sintomas de amarelecimento, murcha, seca e escurecimento do sistema vascular pode ser um indicativo que o agente etiológico da doença seja do gênero Fusarium. Havendo a suspeita o material deve ser encaminhado ao laboratório para análise fitopatológica.
Para o diagnóstico é de extrema importância que a coleta do material vegetal doente seja realizada de forma correta, o que possibilita um diagnóstico preciso da doença.
É necessário recolher uma seção do caule ortotrópico, preferencialmente de plantas com estádios iniciais de evolução dos sintomas da MFCC.
Plantas completamente secas e em estádio de decomposição podem conter, além do patógeno, microrganismos saprófitas/decompositores que dificultam e/ou mascaram o diagnóstico correto da doença, proporcionando um laudo falso-negativo.

Uma vez que as amostras foram coletadas, estas devem ser preparadas para que sejam levadas ao laboratório para análise fitopatológica, sendo 24 horas o prazo máximo entre a coleta do material e a chegada ao laboratório.
As amostras devem ser acondicionadas em sacos plásticos contendo em seu interior um pedaço de algodão umedecido para evitar desidratação da amostra, porém sem proporcionar molhamento excessivo.
Posteriormente, essas amostras devem ser colocadas em caixa de isopor ou papelão para serem transportadas e preservadas até chegar ao laboratório.
Além disso, é necessário fazer anotações para o preenchimento da ficha de diagnose, e fornecer informações acerca do material coletado para auxiliar na diagnose.
São necessárias informações tais como: data de coleta, sintomas, idade da planta, variedade/cultivar da planta hospedeira, se a planta amostrada está em plantio comercial, quintal, jardim ou outra condição, a localização da área, histórico de doenças na lavoura, tipo de solo, condições climáticas, manejo cultural da lavoura, etc.
Ciclo das relações patógeno-hospedeiro
O ciclo de vida de um fungo pode iniciar-se com um esporo que serve como fonte primária de inóculo e, à medida que esse esporo produz mais esporos, ciclos secundários da doença ocorrem; até que o patógeno chegue a sua fase de repouso pela produção de estruturas de resistência sendo importante considerar também no ciclo de vida as suas fases sexual e assexual (Baudoin, 2001).
No ciclo de vida de qualquer fitopatógeno ocorrem eventos relacionados ao desenvolvimento da doença, quais sejam: sobrevivência, disseminação, penetração, infecção, colonização e reprodução (Nelson et al., 1981).
A seguir serão descritos os principais os eventos supracitados para patógenos do gênero Fusarium spp. (Bedendo, 2018), para que mais adiante seja estabelecida uma analogia entre esses conhecimentos com aqueles descritos por Belan et al., (2018) para a MFCC do cafeeiro conilon.
A sobrevivência de patógenos do gênero Fusarium ocorre na forma de micélio e clamidósporos (esporos de resistência) encontrados geralmente em restos de cultura. Na ausência do hospedeiro principal o fungo pode ainda sobreviver em plantas hospedeiras alternativas.
A disseminação pode ocorrer a curta e a longa distância. No primeiro caso o principal veículo de disseminação é a água de chuva e/ou irrigação e a movimentação do solo (aração/gradagem).
Já a longas distâncias as principais formas de disseminação são mudas contaminadas, podendo ocorrer, em alguns casos, através de sementes contaminadas, porém para cafeeiro conilon, essa disseminação via sementes ainda não foi comprovada.
Após a disseminação, os esporos do patógeno precisam germinar para infectar e colonizar os tecidos do hospedeiro. Os exsudatos radiculares estimulam a germinação dos esporos do fungo e, com isso, ocorre à etapa subsequente, a penetração.
Os patógenos do gênero Fusarium penetram através de ferimentos ou diretamente pela raiz principal, radicelas ou pelos absorventes para dar início à colonização do tecido.
Após a infecção, as hifas crescem intercelularmente em direção aos vasos do xilema, e a partir daí o patógeno distribui-se para as demais partes da planta através de hifas ou conídios que seguem o fluxo da seiva bruta.
À medida que a doença evolui, ocorre a obstrução e o escurecimento dos vasos. A obstrução se dá pela constrição dos vasos e também pelo acumulo de esporos, micélio, gomas e tiloses.
Vale destacar ainda que alguns polissacarídeos e toxinas formados pelo fungo contribuem para o bloqueio dos vasos. Essas toxinas podem atingir as folhas acarretando redução na síntese de clorofila e alterações na fotossíntese.
A murcha das plantas deve-se ao bloqueio dos vasos. Devido ao ataque sistêmico, as sementes podem ser infectadas.
Quando a planta morre o fungo pode crescer em tecidos em decomposição, onde tem início a etapa de reprodução. A reprodução ocorre através de esporos e clamidósporos. Temperaturas variando de 21 a 33º C (ótima = 28º C) são favoráveis para a reprodução do patógeno.
Qualquer uma das etapas o ciclo de vida de Fusarium spp., descritas acima pode apresentar variações, já que existem muitas espécies desse fungo associadas a diferentes espécies botânicas, além disso F. oxysporum pode apresentar as ‘formae speciales’, que podem ainda ser divididas em raças baseado em suas especializações patogênicas em diferentes plantas hospedeiras (Nelson et al., 1981).
No Brasil, Belan et al., (2018) relataram que plantas de C. canephora L. murcham e morrem nas principais regiões produtoras e devido à infecção por F. decemcellulare, F. lateritium e F. solani.
Como essa doença foi descrita recentemente para café conilon no Brasil, estudos epidemiológicos ainda estão sendo realizados para elucidar com clareza as relações patógeno-hospedeiro.
Assim, na ausência dessas informações, serão apresentadas no Quadro 1 o resumo das etapas conhecidas do ciclo de vida de Fusarium spp., agente etiológico das murchas vasculares (Bedendo, 2018), e comparar-se-á essas etapas àquelas descritas até o momento por Belan et al. (2018).

Embora Bedendo, (2018) cite que uma das formas de sobrevivência de Fusarium spp. seja por meio de clamidósporos, Belan et al., (2018) não relataram a presença dessas estruturas para nenhuma das espécies estudadas.
Vicente et al., (2012) também não notaram a presença de clamidósporos de F. decemcellulare e relataram que primariamente o patógeno sobrevive saprofiticamente em tecidos mortos do córtex de cacau.
Segundo Booth and Waterston, (1964), F. decemcellulare é disseminado por macroconídios produzidos em esporodóquios em hastes mortas e ramos, microconídios desenvolvidos a partir de micélios presentes em tecidos infectados, e ascósporos produzidos em tecidos vegetais em decomposição.
Belan et al. (2018) também relataram a presença de esporodóquios para F. decemcellulare e F. solani em meio de cultura BDA.
Para a cultura do cacaueiro, a ocorrência de F. decemcellulare é mais comum em árvores com algum tipo de estresse seja este biótico ou abiótico.
O fungo pode sobreviver como micélio vegetativo no córtex e nas bordas das lesões do cancro no hospedeiro. Já os esporos sobrevivem em corpo frutificação (Vicente et al., 2012).
Embora Belan et al., (2018) não tenham relatado a fase sexuada de F. decemcellulare, F. lateritium e F. solani, Ford et al. (1967) relataram que peritécios de F. decemcellulare são produzidos em pequenos grupos formando um estroma que emerge através do córtex produzindo ascósporos durante o período chuvoso, sendo esses disseminados pelo vento ou chuva.
De acordo com Trindade e Poltronieri (1997), F. solani apresenta clamidósporos como estrutura de resistência e a fase sexuada com formação de peritécio contendo ascósporos, sendo a disseminação por meio de ascósporos, macroconídios, microconídios do fungo principalmente pelo vento, água e homem.
Vale destacar que F. lateritium também apresenta macro, microconídios e clamidósporos (Cambuim et al., 2007).

Estudos epidemiológicos sobre o patossistema Fusarium spp.- Coffea canephora são necessários, pois o patógeno tem se disseminado rapidamente em diferentes regiões do Brasil e causado danos em cultivares/genótipos suscetíveis, assim, o entendimento detalhado do ciclo de vida dessas três espécies de Fusarium em cafeeiro conilon irá contribuir para o seu manejo.
Epidemiologia
São recentes os estudos da MFCC no Brasil. Em outros países como a Uganda, uma doença semelhante à MFCC, denominada Coffee wilt disease (CWD) ou traqueomicose (Fusarium xylarioides) tornou-se endêmica, porém, assim como para a MFCC, informações sobre a epidemiologia da CWD também são escassas (Phiri e Baker, 2009).
Para CWD foi descrita uma taxa de infecção próxima a 10 % ao ano, com padrão de distribuição da epidemia no início aleatório evoluindo para agregado ao longo do tempo, porém os autores não conseguiram concluir quanto à forma de disseminação do patógeno, sendo esta ainda uma incógnita (Musoli et al., 2008).
Os tratos culturais do cafeeiro conilon como, por exemplo, a poda realizada por serrote, foice, tesoura e/ou motosserra podem estar associadas à disseminação do patógeno. Na África a disseminação com o uso do facão foi comprovada por Phiri e Baker (2009).
A transmissão por contato de raízes já foi identificada no caso de murcha em culturas perenes devido a F. oxysporum f. sp. elaïdis em dendezeiro (Elais guineenses) por Franqueville e Diabaté (1995).
Para o cafeeiro conilon só há suspeita, nada ainda conclusivo. Pesquisas estão sendo realizadas pelos autores para confirmar a hipótese sobre a possibilidade de disseminação via sementes e/ou estacas para produção de mudas.
Pesquisas para compreender a epidemia desta doença, estão sendo realizadas em lavouras tanto de propagação seminíferas (Lavoura seminífera) quanto de propagação vegetativa (Lavoura Clonal) (Figura 3).

Nossa equipe está avaliando a epidemia da doença nos dois sistemas de cultivos, em locais distintos. Até o momento foi identificado o padrão aleatório de distribuição espacial das plantas doentes no início da epidemia, evoluindo para padrão agregado com o passar do tempo.
Muitas informações estão sendo coletadas e em breve serão divulgados os resultados que irão fornecer informações importantes para o programa de manejo integrada da doença.
Manejo da MFCC
Diversas práticas podem ser utilizadas para o manejo da Murcha Fusarium do Cafeeiro Conilon (MFCC). Talvez as mais eficientes sejam o plantio de variedades/clones resistentes, uso de materiais de plantio livres da doença e prevenção/tratamento de ferimentos nos cafeeiros.
Outros métodos culturais incluem a desinfestação de implementos agrícolas (facões, serrotes e serras de poda), o desenraizamento e a queima in situ de cafeeiros doentes, quarentena, controle químico, etc.
Neste capítulo serão discutidos os métodos de manejo disponíveis e aqueles que poderão estar disponíveis no futuro a partir dos resultados de pesquisas.
Plantio de variedades/clones resistentes
O uso de variedades/clones resistentes é um método eficiente e econômico para o gerenciamento de doenças do cafeeiro (Teferi e Belachew, 2018).
É um método ambientalmente favorável como à maioria dos métodos de controle cultural, em decorrência da efetividade no manejo das doenças e ausência do uso de defensivos químicos.
Quando uma doença semelhante à MFCC, denominada Coffee wilt disease (CWD) ou traqueomicose (Fusarium xylarioides), ocorreu pela primeira vez em 1927 no continente africano, o uso de variedades resistentes em combinação com métodos culturais reduziu o impacto da doença (Phiri et al., 2009).
Alguns pesquisadores (Fraselle, 1950; Deassus, 1954; Porteres, 1959) relataram diferenças varietais na resistência à CWD e sugeriram o uso de variedades resistentes como estratégia de manejo.
Cultivares de C. canephora (notavelmente do grupo robusta), com resistência à doença, formaram a base de programas de melhoramento genético do cafeeiro conilon em muitos dos países da África Ocidental (Phiri et al., 2009).
A resistência à CWD nos países africanos também tem sido buscada em híbridos cultivados de C. canephora, C. arabica × C. canephora, espécies de cafeeiros silvestres e cafeeiros cultivados fora da África (Rutherford, 2006).
Em Uganda, oito clones resistentes foram identificados por inoculação artificial e triagem de campo (Phiri et al., 2009).
Perspectivas para o manejo efetivo da MFCC em C. canephora no Brasil são baseadas na resistência do hospedeiro, e os esforços atuais de pesquisa também estão direcionados nesse sentido.
Quando clones de C. canephora são plantados em fileiras, cada linha compreendendo um clone diferente, os danos e perdas à cultura devido à MFCC podem ser reduzidos.
Além da resistência genética natural das plantas, o plantio de clones resistentes pode auxiliar reduzindo a disseminação do patógeno.
Tal fato está associado à restrita disseminação do patógeno apenas dentro das fileiras, e não entre fileiras adjacentes, constituídas por clones com diferentes níveis de resistência genética (Rutherford, 2006).
Uso de materiais de plantio livres da doença
O agente etiológico da MFCC pode ser disseminado via materiais de plantio. A disponibilidade de materiais de plantio sadios é um desafio no momento devido à falta de variedades ou clones resistentes à MFCC.
Mudas de C. canephora além de abrigar o patógeno em seu interior colonizando os feixes vasculares, também podem disseminar o patógeno contido no solo aderido às suas raízes, e/ou via esporos transportados em seus caules e ramos.
Plantas matrizes assintomáticas, porém, infectadas, podem dar a falsa impressão de sanidade do material propagativo (estacas).
Logo, produtores de mudas devem solicitar acompanhamento de profissionais treinados e análises laboratoriais para atestar a sanidade dos jardins clonais e mudas produzidas.
Mudas clonais provenientes de fontes confiáveis, como viveiros e jardins clonais registrados, podem reduzir e/ou eliminar o risco de disseminação e introdução do patógeno em áreas isentas.
Além disso, produtores de mudas devem utilizar solo proveniente de áreas sem o potencial de abrigar o patógeno, como terras virgens ou sem histórico de cultivo de cafeeiros.
A esterilização do solo via solarização é outra opção para eliminar o inóculo do solo, mas isso pode ser caro e demorado.
Embora seja um assunto de debate, existe o potencial da disseminação ocorrer via sementes. Girma e Hindorf (2001) demostraram que sementes não transmitiam F. xylarioides, agente etiológico da CWD em C. arábica na Etiópia.

É importante destacar, no entanto, que Fusarium spp. são um patógeno de colonização sistêmica que afeta os feixes vasculares e, portanto, a transmissão via sementes de cafeeiro pode ser possível, mesmo que não tenha sido confirmada até o momento (Phiri et al., 2009).
Prevenção e tratamento de ferimentos nos cafeeiros
Fusarium spp. penetra em plantas de cafeeiro através de feridas em seus órgãos/tecidos. Portanto, qualquer ação que proporcione feridas nas plantas contribuirá para a ocorrência da doença.
Diversas práticas de manejo precisam ser realizadas para fins de aumentar e/ou garantir a produção da lavoura, porém essas causam ferimentos nos cafeeiros.
Quando ocorre algum ferimento na planta, seja esse proposital durante a realização da poda, ou acidental durante as práticas de manejo como, por exemplo, de plantas daninhas, os tecidos da planta ficam expostos, tornando uma porta de entrada para o patógeno.
Logo, essa pode ser uma das razões para expansão da ocorrência da MFCC nas principais áreas de cultivo do cafeeiro (Coffea spp.).
Em relação à prática cultural da poda, lavouras de café conilon geralmente são submetidas ao sistema de poda programada de ciclo (Verdin Filho et al., 2014), ou seja, são eliminados os ramos plagiotrópicos e/ou ortotrópicos desgastados após a frutificação.
Além dessas podas de condução da lavoura, podas drásticas (recepas) para renovação das plantas também são realizadas várias vezes durante o ciclo produtivo da lavoura.
Dessa forma, frequentemente ocorrem ferimentos nas plantas ocasionados pela poda de ramos, ou acidentalmente durante as práticas de manejo de plantas daninhas (capina manual ou, em especial, corte por lâminas de roçadoras).
Em campo, nota-se que a maioria dos cafeeiros mortos apresentam ferimentos provenientes dessas práticas.
De fato, as primeiras plantas doentes geralmente são identificadas em lavouras recém-plantadas, logo após o início da realização das práticas de poda.
Além disso, quando são realizadas podas tipo recepa para renovação dos ramos ortotrópicos, os novos ramos que brotam de plantas doentes geralmente secam e morrem na fase inicial de desenvolvimento.
Nos casos em que os ferimentos são inevitáveis, como durante as podas e colheitas, ou quando identificado um ferimento acidental, é aconselhável que os tocos ou os locais dos ferimentos sejam tratados com fungicida.
Um fungicida comum a base de cobre pode ser usada para este propósito. Sugere-se o uso da pasta bordalesa. Para seu preparo, o fungicida à base de cobre deve ser misturado com água na proporção de 1:1:10 (1Kg de cal hidratada + 1Kg Sulfato de Cobre + 10L de água).
Diluir completamente a cal em 5L de água em um recipiente e diluir completamente o sulfato de cobre em 5L de água em outro recipiente. Misturar as duas caldas até formar uma mistura homogênea de consistência quase pastosa.
Agitar constantemente durante o preparo e uso. A pasta bordalesa pode ser aplicada com um pincel na superfície de corte e/ou dos ramos dos cafeeiros, ou a calda bordalesa (1:1:100) pode ser pulverizada nesses possíveis sítios de infecção.
Pincelamento dos caules com tintas à base de oxicloreto de cobre (Kocide®) na proporção de 300 g de fungicida por litro de água foi eficiente para proteger as feridas contra a infecção pelo agente patogênico da CWD, na Ethiópia (Phiri et al., 2009).
Em relação aos ferimentos ocorridos durante as operações de manejo das plantas daninhas, esses devem ser evitados.
Práticas culturais como a aplicação de herbicidas, ou cobertura do solo com palha sob a copa das plantas (mulching), são alternativas para o manejo de plantas daninhas de forma a evitar ocorrência de ferimentos em raízes e caules dos cafeeiros.
O uso dessas práticas reduziu a incidência da CWD nas lavouras de café no continente africano (Phiri et al., 2009).
Ferimentos também ocorrem naturalmente no caule dos cafeeiros ao nível do solo. Essas feridas microscópicas são provocadas principalmente quando os cafeeiros são agitados devido à ação dos ventos, e proporcionam atrito do caule com o solo.
Essas feridas podem, portanto, ser evitadas com a instalação de quebra-ventos, por exemplo, plantio de faixas de bananeiras ou árvores frutíferas, ou árvores de crescimento rápido, em torno da borda das lavouras.
Outra causa de ferimentos nos caules do cafeeiro são os insetos-pragas, como a broca-das-hastes (Xylosandrus compactus ) e cupim-subterrâneo (Coptotermes gestroi ), que podem fornecer pontos de entrada para o patógeno nos tecidos do cafeeiro e/ou dissemina-lo de plantas doenças para plantas sadias.
Phiri et al. (2009) descreveram que insetos-pragas são suspeitas de transmitir F. xylarioides, agente etiológico da CWD, entre cafeeiros no continente africano.
Logo, essas pragas devem ser controladas para evitar o favorecimento à ocorrência da MFCC, além de prevenir perdas diretas na colheita causadas pelo dano causado por esses insetos.
Desinfestação de ferramentas de corte
A superfície recém-cortada ou ferida dos cafeeiros fornece uma área de superfície que pode funcionar como ponto de entrada para o patógeno.
Além disso, as ferramentas utilizadas em práticas de manejo cultural da lavoura (serra de poda, serrotes, facões e foices, enxadas, lâminas de roçadora, etc) podem atuar como veículo para disseminação do patógeno.
Quando essas ferramentas são utilizadas ou entram em contato com plantas doentes mesmo que assintomáticas, estruturas de propagação do patógeno podem ficar aderidas às ferramentas.
Posteriormente, quando essas são colocadas em contato com plantas sadias, introduzem o patógeno diretamente nos tecidos do hospedeiro, favorecendo a infecção e desenvolvimento da doença.

Logo, sugere-se que os implementos devem ser inflamados sobre o fogo ou banhados com desinfestantes (álcool, hipoclorito de sódio ou amônia quaternária) antes de cortar cada haste ou depois de cortar algumas hastes, para que sejam esterilizadas, particularmente em lavouras com histórico da MFCC.
Outra opção seria fazer inicialmente uma vistoria em todas as linhas de cultivo da lavoura para identificar e marcar as plantas com sintomas de MFCC. Posteriormente deve ser realizada a poda apenas das plantas sadias, e por último, fazer a poda das plantas sintomáticas.
Desenraizamento e queima das plantas doentes (roguing)
Arrancar e queimar plantas com sintomas de murcha é provavelmente um dos mais antigos métodos de manejo de doenças cujos patógenos são do gênero Fusarium.
O método funciona removendo a fonte do inóculo do patógeno, evitando a disseminação e aumento do número de plantas doentes.
Envolve a inspeção frequente da lavoura para identificar plantas com sintomas nos estágios iniciais da doença.
O treinamento de agricultores e técnicos para a identificação dos estágios iniciais da expressão dos sintomas é crucial para o diagnóstico precoce e, portanto, para melhores chances de erradicação ou redução do inóculo.
Eliminar o cafeeiro que já morreu pode ser tarde demais, e o patógeno pode já ter sido disseminado para cafeeiros vizinhos.
Uma vez identificadas às plantas de cafeeiros doentes, estas devem ser arrancadas, cavando para extração de todo sistema radicular, e depois queimadas.
Essa queima deve ser realizada no local/buraco onde a planta foi arrancada, ou devidamente ensacada para não dispersar inóculo do patógeno durante o transporte, e levada para fora da lavoura para incineração.
O descarte correto de material de café infectado é crucial no manejo da MFCC, pois a casca, as raízes e as hastes podem conter o patógeno na forma de esporos, hifas e corpos de frutificação (CAB International , 2006).
Embora a identificação precoce dos sintomas, o desenraizamento e a queima das plantas de cafeeiros infectadas em estágio inicial sejam cruciais para o manejo da MFCC (Phiri et al., 2009), podem ocorrer alguns problemas visto que as plantas possam não estar suficientemente secas e assim não queimarem facilmente.
A melhor maneira de executar a queima de cafeeiros recém-infectados é, portanto, cortar os caules em pedaços menores, o que promove a secagem rápida, e esses pedaços são empilhados no buraco onde a planta de cafeeiro infectada foi arrancada.
Para reduzir o risco de inoculação em plantas adjacentes, as plantas que circundam as plantas doentes também precisam ser arrancadas e queimadas.
Quando a intensidade da CWD em lavouras do continente africado é considerada alta, por exemplo, 70% dos cafeeiros doentes, Phiri et al. (2009) recomendaram eliminar todos os cafeeiros da lavoura e replantar com variedades/clones resistente ou tolerante.
No entanto, patógenos do gênero Fusarium, como os agentes etiológicos da MFCC e CWD, são considerados endêmicos e habitantes do solo.
Embora a maior parte dos tecidos das plantas doentes seja eliminada, parte pode permanecer no solo e é fonte potencial de inóculo.
Tal inóculo pode ser reduzido após um período de pousio de pelo menos 2 anos (Wrigley, 1988; Phiri et al., 2009) antes de replantar na mesma área, e/ou rotação de culturas com espécies não hospedeiras do patógeno.
Quarentena
A quarentena é um importante método de controle cultural da MFCC e tem como objetivo impedir o movimento de material vegetal infectado, solo e implementos infestados para áreas onde não há histórico de ocorrência da doença. A quarentena pode ser realizada a nível de propriedade, nacional e internacional.
É crucial que um agricultor realize a quarentena para limitar a disseminação do patógeno em sua (s) propriedade (s) e/ou talhões de uma mesma propriedade.
Essa prática inclui a realização das práticas culturais (manejo de plantas daninhas, colheita, poda, desbrota, etc) inicialmente na(s) propriedade(s)/talhão(ões) não afetada(s), e por último na(s) propriedade(s)/talhão(ões) afetada(s).
Assim é possível minimizar ou eliminar a disseminação do patógeno dentro e entre propriedades. Isso ocorre porque o patógeno pode ser disseminado via implementos agrícolas contaminados, mesmo em roupas e sapatos/pés quando o agricultor estiver em contato com os cafeeiros doentes ou solo contaminado fica aderido nos sapatos / pés ou nos implementos agrícolas (Phiri et al., 2009).
O intercâmbio ou entrada na propriedade de material vegetal (mudas, estacas, sementes, etc) de sanidade desconhecida, e de implementos agrícolas deve ser desencorajado para reduzir o risco de propagação da MFCC.
Recomenda-se limpeza e desinfestação de implementos agrícolas vindos de outras propriedades, antes da entrada na propriedade ou talhão onde não há relatos de ocorrência dessa doença.

Controle biológico
O controle biológico é definido como o uso de um organismo vivo para controlar ou transformar outro organismo vivo.
Agentes de controle biológico (inimigos naturais) ainda não foram selecionadas e nem tiveram atividade inibitória comprovada para o controle biológico dos agentes etiológicos da MFCC.
No entanto, Rabechault (1954) relatou que quatro actinomicetos, uma bactéria, Corticium, Marasmius e Trichoderma spp. exerceram efeitos inibitórios sobre F. xylarioides.
Logo, o controle biológico pode ter um grande potencial para o controle da MFCC, atuando, por exemplo, como um selante para as feridas nos tecidos dos cafeeiros (Phiri et al., 2009), e isso deve ser investigado.
Controle Químico
Defensivos químicos também já foram sugeridos como uma medida de manejo das “fusarioses” do cafeeiro (Gaudy, 1956; Saccas, 1956), mas seu efeito é provavelmente limitado devido ao fato do patógeno colonizar os feixes vasculares da planta (Rutherford, 2006).
Portanto, controlar essas doenças com produtos químicos é uma opção difícil e de baixa eficiência até o momento (Phiri et al., 2009). Logo, a melhor maneira de controlar a MFCC é o uso variedades/clones resistentes ou impedir que a infecção ocorra.
O patógeno requer feridas para infecção, e assim, um método para o manejo da MFCC é, portanto, tratar as feridas ocorridas durante práticas culturais. Os fungicidas à base de cobre podem ser usados para selar os ferimentos conforme descrito anteriormente.
Além de usar fungicidas para selar os ferimentos, estudos sobre a pulverização dos caules ou a pintura dos primeiros 50 cm de um caule de cafeeiro acima do nível do solo com um fungicida à base de cobre proporcionaram redução da incidência de CWD em lavouras na Etiópia, Uganda, Tanzânia e República Democrática do Congo (Phiri et al., 2009).
Em suas pesquisas, Gaudy (1956) demonstrou que a pulverização de caules de cafeeiros com oxicloreto de cobre foi eficaz no manejo da CWD.
Assim também Kalonji-Mbuyi et al. (2009) demonstraram que ocontrole químico realizado por pulverização mensal de Cupravit (oxicloreto de cobre) a 0,5% (peso/vol) na base do tronco de cafeeiros foi eficaz na redução da incidência de CWD em lavouras da República do Congo (Phiri et al., 2009).
Existe, portanto, potencial para o uso de fungicidas à base de cobre para o manejo da MFCC, mas a sua viabilidade deve ser avaliada.
O controle da MFCC com fungicidas sistêmicos pode ser uma opção alternativa, mas, novamente, sua viabilidade econômica e eficiência provavelmente é baixa, e o risco de contaminação dos grãos de café com o fungicida deve ser investigado (Phiri et al., 2009).
Estudos preliminares com benomyl, em condições de casa-de-vegetação, em Uganda, demonstraram que o fungicida pode controlar a CWD, mas há necessidade de aplicações frequentes a cada mês (Phiri et al., 2009).
Vale ressaltar, que após o uso generalizado do benomyl, este um fungicida sistêmico foliar de amplo espectro, houve na década de 1960 os primeiros problemas relacionados a resistência de fungo a fungicidas, o que ocasionou a retirada do mesmo do mercado.
O uso de fungicidas sistêmicos mesmo sendo antieconômico para controlar a MFCC, pode ser a única solução para salvar materiais de germoplasma de café com características agronômicas de importância (produtividade, resistência à seca, etc), porém suscetíveis a MFCC.
Muitos países afetados pela CWD no continente africano perderam/estão perdendo parte de seu banco de germoplasma em decorrência dessa doença (Phiri et al., 2009).
Porém o uso de fungicidas sistêmicos em escala comercial precisa ser investigado.
Manejo Integrado de doenças
O manejo integrado de doenças (MID) é uma abordagem integrada para o gerenciamento da sanidade das culturas. O MID envolve o uso integrado de tantos métodos de manejo quanto possível para minimizar danos e perdas proporcionados por doenças de plantas.
Os componentes do MID devem ser utilizados de maneira sistemática, e deve incluir um programa de monitoramento da distribuição espacial e temporal da doença para que os componentes do manejo sejam escolhidos e combinados para gerenciar a doença de maneira eficaz.
A capacitação de extensionistas e agricultores, e a disseminação de informações são cruciais para a abordagem do MID.
O manejo integrado da MFCC envolve a seleção e aplicação de uma gama harmoniosa das estratégias de manejo descritas acima, e, portanto, pode incluir uma combinação de alguns ou todos os seguintes métodos:
(1) uso de variedades/clones resistentes ou tolerantes;
(2) equilíbrio nutricional das plantas;
(3) uso de material de plantio saudável;
(4) quarentena;
(5) eliminar plantas e materiais vegetais infectados;
(6) controle de insetos pragas que predispõem as plantas à infecção;
(7) uso de práticas culturais alternativas para prevenir ferimento dos cafeeiros durante o manejo de ervas daninhas;
(8) escolha de um campo sem histórico de ocorrência da doença para estabelecer novas lavouras;
(9) pousio e/ou rotação de culturas com espécies não hospedeiras do patógeno;
(10) prevenção da disseminação do patógeno no campo;
(11) uso de defensivos biológicos e/ou químicos, etc.
Considerações Finais
Nosso entendimento sobre a MFCC é limitado até o momento. A geração de novos conhecimentos é uma necessidade fundamental e será de grande benefício na prevenção da disseminação e manejo desta doença.
É importante que pesquisadores, produtores e extensionistas sejam treinados na identificação da MFCC principalmente dos estágios iniciais da doença, para reduzir a possibilidade de diagnósticos incorretos, disseminação do patógeno e recomendações de manejo desnecessárias, dispendiosas e/ou ineficientes.
As práticas fitossanitárias recomendadas, como por exemplo, a desinfecção de ferramentas, tratar feridas das plantas e o desenraizamento e a queima de cafeeiros doentes, proporcionam benefícios, mas sua adoção pode ser limitada por falta de recursos na propriedade/produtor.
Logo, perspectivas para o manejo efetivo da MFCC em Coffea spp. no Brasil são baseadas na resistência do hospedeiro e conhecimento dos aspectos epidemiológicos da doença para auxiliar na tomada de decisão e direcionamento das práticas integradas de manejo. Nossos esforços atuais de pesquisa estão focados nesse sentido.
Se você tem interesse em saber mais sobre as Pragas e Doenças do Café: Arábica e Conilon, te convido a conhecer a plataforma da AgricOnline. Ao fazer a sua assinatura, você tem acesso ilimitado a todos os cursos da plataforma. São cursos que vão desde produção vegetal, produção animal, mercado e carreira.
Ao término de cada curso, você tem direito ao certificado com a carga horária de cada curso, clique no link para conhecer.

Ou clique no link:
https://go.agriconline.com.br/pass/?sck=portal
Fonte
PARTELLI, Fábio Luiz; ESPINDULA, Marcelo Curitiba. Café Conilon: Conhecimento para Superar Desafios. Alegre - ES: CAUFES, 2019.